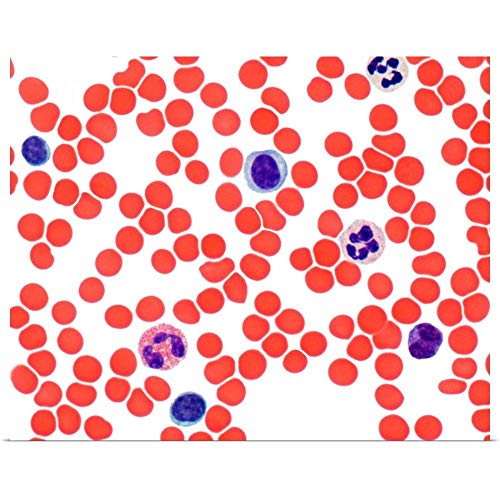
GREATBIGCANVAS Blood Smear Unframed Poster Print

Are you looking for the best human blood smears to explore the fascinating world of blood cells? Discover our top picks of carefully prepared microscope slides that offer clear views and sharp details, making learning fun and engaging for students, teachers, and science enthusiasts alike.
Human blood smears are a fascinating way to explore the tiny world of blood cells. These microscope slides bring science to life, making learning fun and engaging. Whether you’re a student, teacher, or science enthusiast, there’s something here for everyone.
Discover the best human blood smears that offer clear views and sharp details. Each slide is carefully prepared to help you learn and observe with ease. From basic blood components to specific conditions, these tools make science accessible.
Explore our top picks and find the perfect slide for your needs. With trusted brands and high-quality materials, you’ll learn with confidence. Dive in and see the wonders of human blood like never before!
List of Top 10 Human Blood Smears
| Image | Title | Best For | Price |
|---|---|---|---|
![]() |
Discovering Human Blood Self-Study Unit, Microscope Slide Set |
This Discovering Human Blood Self-Study Unit is perfect for anyone who wants to learn about blood in a simple and fun way. It’s great for students, homeschoolers, or science enthusiasts of all ages. |
|
![]() |
United Scientific Supplies 500-9 “Human Blood Smear, Wright’s Stain” Prepared Microscope Slide |
This prepared microscope slide is perfect for students and beginners in biology or medical studies. It’s easy to use and great for learning about human blood cells. |
|
![]() |
Human Male Blood Film Slide, Smear |
The Human Male Blood Film Slide, Smear is perfect for students, teachers, and health professionals who need a clear, reliable tool for studying blood cells. It is great for anyone learning or teaching about blood under a microscope. |
|
![]() |
Carolina Human Sickle Cell Anemia Slide, Smear, Wright’s Stain |
This Carolina Human Sickle Cell Anemia Slide is perfect for students and educators studying blood disorders. It’s a great tool for learning about sickle cell anemia in a clear and simple way. |
|
![]() |
GREATBIGCANVAS Blood Smear Unframed Poster Print |
This bold and unique poster print is perfect for anyone who wants to add a touch of modern art to their space. It’s great for those who love eye-catching designs and want to make a statement in their living room, bedroom, or office. |
|
![]() |
GREATBIGCANVAS Blood Smear Unframed Poster Print |
This bold, eye-catching poster is perfect for anyone who wants to add a unique touch to their living space. Whether you’re decorating a dorm room, office, or home, this high-quality print will stand out and spark conversation. |
|
![]() |
GREATBIGCANVAS Blood Smear, Light Micrograph Canvas Wall Art Print, Home Decor Artwork, 30″x24″ |
This canvas wall art is perfect for anyone who wants to add a unique touch to their home or office. It’s great for those who love science-inspired decor or want a conversation starter in any room. |
|
![]() |
Human Blood Film Slide, Smear, Wright’s Stain |
This Human Blood Film Slide is perfect for students, teachers, and science enthusiasts. It’s great for learning about blood cells in a simple, clear way. |
|
![]() |
Blood Smear Human – Microscope Slide |
This Blood Smear Human – Microscope Slide is perfect for students and beginners in biology or medical studies. It’s easy to use and clearly labeled, making learning simple. |
|
![]() |
GSC International Blood Smear Human – Microscope Slide |
This microscope slide is perfect for students and teachers who want to study human blood. It’s easy to use and clearly labeled, making it great for learning. |
Detailed Reviews
Discover the top 10 Human Blood Smears in our expert-curated guide. Each product is thoroughly reviewed for quality, clarity, and value, ensuring you find the perfect fit for your needs. Whether you’re a student, educator, or enthusiast, this guide makes choosing easy and confident.
1. Discovering Human Blood Self-Study Unit, Microscope Slide Set

Explore the wonders of human blood with this self-study unit. It comes with a microscope slide set, perfect for hands-on learning. Discover the basics of blood components in a simple, engaging way.
Carolina offers unmatched support for your learning journey. Reach out via live chat, email, or phone during business hours. We’re here to help you every step of the way.
Since 1927, Carolina has been a trusted name in science education. We serve educators, hobbyists, and professionals worldwide with top-quality materials. Learn with confidence using our proven resources.
| Pros | Cons |
|---|---|
|
|
Perfect For:
This Discovering Human Blood Self-Study Unit is perfect for anyone who wants to learn about blood in a simple and fun way. It’s great for students, homeschoolers, or science enthusiasts of all ages.
Ready to Purchase?
2. United Scientific Supplies 500-9 “Human Blood Smear, Wright’s Stain” Prepared Microscope Slide

Discover the United Scientific Supplies 500-9 microscope slide. It shows a human blood smear clearly. The slide uses Wright’s Stain for sharp detail.
This slide is small and light. It measures just 3.0 x 0.5 x 1.0 inches. It weighs only 0.1 pounds. It comes from India.
This is a great tool for learning. It helps you see blood cells easily. Perfect for students and labs.
| Pros | Cons |
|---|---|
|
|
Perfect For:
This prepared microscope slide is perfect for students and beginners in biology or medical studies. It’s easy to use and great for learning about human blood cells.
Ready to Purchase?
3. Human Male Blood Film Slide, Smear

Explore the Human Male Blood Film Slide, Smear from Carolina Biological Supply Company. This educational tool is perfect for learning about blood cells and their structure. It’s a hands-on way to study science.
Carolina has been a trusted supplier since 1927. We serve teachers, students, and professionals worldwide. Our science materials are designed for all levels of learning.
Need help? We’ve got you covered. Technical support is available Monday to Friday, 8:00am to 6:00pm ET. Live chat runs from 8am to 5:30pm ET. Contact details are provided after your order.
| Pros | Cons |
|---|---|
|
|
Perfect For:
The Human Male Blood Film Slide, Smear is perfect for students, teachers, and health professionals who need a clear, reliable tool for studying blood cells. It is great for anyone learning or teaching about blood under a microscope.
Ready to Purchase?
4. Carolina Human Sickle Cell Anemia Slide, Smear, Wright’s Stain

Carolina Human Sickle Cell Anemia Slide is a microscope slide that shows a human blood smear. It comes from a person with sickle cell anemia.
The slide is stained with Wright’s stain, making it easy to see the sickle-shaped red blood cells. This helps students and researchers learn about the condition.
Shop with confidence! Carolina offers unparalleled technical support from 8am to 6:30pm ET, Monday through Friday. Live chat is available from 8am to 5:30pm ET, Monday-Friday.
| Pros | Cons |
|---|---|
|
|
Perfect For:
This Carolina Human Sickle Cell Anemia Slide is perfect for students and educators studying blood disorders. It’s a great tool for learning about sickle cell anemia in a clear and simple way.
Ready to Purchase?
5. GREATBIGCANVAS Blood Smear Unframed Poster Print

Brighten any room with the GREATBIGCANVAS Blood Smear Unframed Poster Print. Its bold design adds a unique touch to your space.
This 24″ W x 19″ H poster ships rolled and ready to hang. It’s made in the USA with high-gloss paper and archival inks for lasting color.
Perfect for living rooms, offices, or dorms. Satisfaction guaranteed—contact us if you’re not happy.
| Pros | Cons |
|---|---|
|
|
Perfect For:
This bold and unique poster print is perfect for anyone who wants to add a touch of modern art to their space. It’s great for those who love eye-catching designs and want to make a statement in their living room, bedroom, or office.
Ready to Purchase?
6. GREATBIGCANVAS Blood Smear Unframed Poster Print
GreatBigCanvas Blood Smear Unframed Poster Print is a bold and eye-catching piece. It measures 36″ W x 29″ H and is perfect for any room.
This high-quality print is made in the USA using archival inks and high-gloss paper. It ships rolled and is ready to hang as-is or frame as desired.
Vivid colors, fine details, satisfaction guarantee. Perfect for any space.
| Pros | Cons |
|---|---|
|
|
Perfect For:
This bold, eye-catching poster is perfect for anyone who wants to add a unique touch to their living space. Whether you’re decorating a dorm room, office, or home, this high-quality print will stand out and spark conversation.
Ready to Purchase?
7. GREATBIGCANVAS Blood Smear, Light Micrograph Canvas Wall Art Print, Home Decor Artwork, 30″x24″

Transform your space with the GREATBIGCANVAS Blood Smear Light Micrograph Canvas. This artwork measures 30″ wide by 24″ high, perfect for adding a bold touch. The canvas is oriented horizontally for easy display.
Each piece is made in the USA with high-quality artist-grade canvas. The vivid colors and fine details are protected by archival inks. It comes ready to hang, with hardware already attached for quick setup.
This wall art fits any room — living room, office, kitchen, and more. If you’re not happy, just reach out for help. Your satisfaction is our promise.
| Pros | Cons |
|---|---|
|
|
Perfect For:
This canvas wall art is perfect for anyone who wants to add a unique touch to their home or office. It’s great for those who love science-inspired decor or want a conversation starter in any room.
Ready to Purchase?
8. Human Blood Film Slide, Smear, Wright’s Stain

Human Blood Film Slide, Smear, Wright’s Stain is a ready-to-use educational tool. It’s perfect for learning about blood cells and their structure.
Carolina Biological Supply Company has over 90 years of experience. They are a trusted source for science teaching materials worldwide.
Easy to use, high-quality, and stained for clarity. Perfect for students and educators alike.
| Pros | Cons |
|---|---|
|
|
Perfect For:
This Human Blood Film Slide is perfect for students, teachers, and science enthusiasts. It’s great for learning about blood cells in a simple, clear way.
Ready to Purchase?
9. Blood Smear Human – Microscope Slide

Blood Smear Human – Microscope Slide is a high-quality specimen for learning. It comes on a glass slide for easy viewing.
The slide is labeled with a description, making it simple to understand. It’s ready to use right away.
This product is perfect for students or anyone studying blood cells. It’s a reliable tool for clear observation.
| Pros | Cons |
|---|---|
|
|
Perfect For:
This Blood Smear Human – Microscope Slide is perfect for students and beginners in biology or medical studies. It’s easy to use and clearly labeled, making learning simple.
Ready to Purchase?
10. GSC International Blood Smear Human – Microscope Slide

The GSC International Blood Smear Human is a high-quality specimen on a glass slide. It is perfect for learning about human blood cells.
Each slide is clearly labeled with a detailed description. This makes it easy to understand what you’re seeing under the microscope.
Great for students, teachers, or anyone curious about science. Ready to use right out of the box.
| Pros | Cons |
|---|---|
|
|
Perfect For:
This microscope slide is perfect for students and teachers who want to study human blood. It’s easy to use and clearly labeled, making it great for learning.
Ready to Purchase?
Buying Guide
Human blood smears are a fun way to learn about blood cells. They make science easy and engaging.
Buying the best human blood smears can be exciting. Here’s how to pick the right one for you:
- Purpose: Think about why you need it. Is it for school, work, or fun? Choose one that fits your goal.
- Quality: Look for clear views and sharp details. High-quality slides make learning easier.
- Stain Type: Some slides use Wright’s Stain. This helps see blood cells better.
- Brand: Pick trusted brands like Carolina or United Scientific. They offer reliable products.
- Size: Check the slide size. Smaller ones are easy to handle and store.
- Support: Choose brands with good support. Help should be easy to reach when needed.
- Price: Find one that fits your budget. Quality doesn’t always mean expensive.
- Packaging: Ensure it’s well-packed to avoid damage during shipping.
With these tips, you’ll find the perfect human blood smear for your needs. Happy learning!